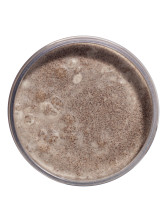

Вы массажист, мастер-эстетист, мастер маникюра, у вас салон?
Регистрируйтесь за 3 минуты, чтобы видеть оптовые цены на все по ссылке https://black-orchid.info/signup/
Подарочный набор "Черная орхидея" от Aroma Fusion - приятный подарок девочке, девушке и женщине на день рождения или на новый год! В состав Beauty Box входят 3 продукта: крем лосьон Папайя, соль морская ароматизированная Цитрус, сахарный скраб Райский цитрус (с эфирным маслом грейпфрута). ****Интенсивно увлажняющий, легкий крем лосьон для тела Папайя обеспечит непревзойденное увлажнение и порадует потрясающим летним ароматом тропического фрукта. Лосьон после депиляции обогащен натуральными ценными маслами макадамии, виноградной косточки и карите, дарящими коже мягкость и природную защиту. Лосьон для тела парфюмированный с экстрактом Папайи обеспечит кожу витаминным комплексом для восстановления естественных сил. Лосьон для тела увлажняющий быстро впитывается, не оставляя жирного блеска, прекрасно подойдет для окончания СПА процедуры и маникюра, а так же увлажнит и успокоит кожу после шугаринга и загара. ****Ароматизированная соль для ванны - это чувственное удовольствие, помогает для снятия стресса и синдрома постоянной усталости. Эфирные масла оказывают противовоспалительное действие, укрепляют иммунитет, тонизируют, омолаживают и очищают кожу, помогают в борьбе с лишим весом и целлюлитом. А потрясающий запах соли для ванны детской усиливает выработку эндорфинов, которые улучшают настроение и дарят радость. ****Скраб для тела с эфирным маслом грейпфрута и ухаживающими маслами какао и авокадо обладает антицеллюлитным эффектом, увлажняющим и тонизирующим действием. Выравнивает и тонизирует кожу, может использоваться как скраб для рук. Скраб для тела с маслами позволяет нежно, но тщательно удалить верхний ороговевший слой эпидермиса. Обеспечивая активное скрабирование вначале, сахар приятно тает и становится все более мягким, образуя приятную кремовую структуру у скраба от целлюлита. К тому же достаточно быстро впитываясь, сахар помогает проникать в кожу и другим полезным веществам, содержащимся в скрабе для тела антицеллюлитном Арома Фьюжн.
Состав: крем для рук папайя 100 мл, скраб сахарный райский цитрус 150 мл, соль морская ароматизированная цитрус 150 гр, подарочная коробка.
Домашняя | Да |
Товар со скидкой | Нет |
Вес | 570 г |
Бренд | AROMA FUSION |
Применение | Для тела, Набор средств |